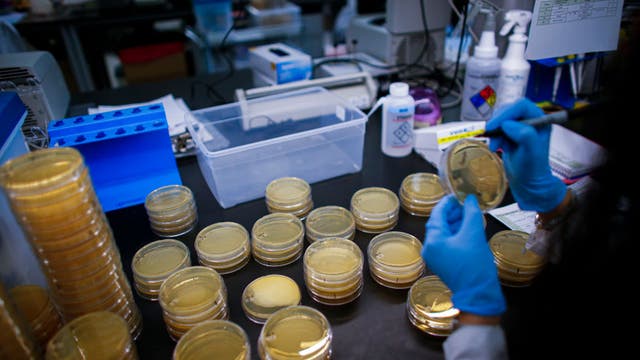
First coronavirus death reported in California; person had been on cruise ship to Mexico

Salesforce to donate to coronavirus, will pay hourly employees and interns
March Benioff said he will pay all of its hourly service providers and interns if they need to stay home sick.
March Benioff said he will pay all of its hourly service providers and interns if they need to stay home sick.
Chef and team serve food to those on stricken cruise ship in Oakland
World Central Kitchen provides food to victims of disaster all around the world.
World Central Kitchen provides food to victims of disaster all around the world.
Passenger describes feeling 'over the edge' being trapped on Princess cruise
All those aboard the ship are expected to disembark over the next several days at the Port of Oakland.
All those aboard the ship are expected to disembark over the next several days at the Port of Oakland.
Crews prepare for cruise ship to dock at Port of Oakland
California Gov. Gavin Newsom explained why "after careful review," the port in Oakland was the "best site."
California Gov. Gavin Newsom explained why "after careful review," the port in Oakland was the "best site."
Passengers cleared to leave Carnival cruise in Long Beach after testing negative for COVID-19
A group of passengers who were being held overnight aboard a Carnival cruise ship in Long Beach have been cleared to leave Sunday after a woman tested negative for COVID-19.
A group of passengers who were being held overnight aboard a Carnival cruise ship in Long Beach have been cleared to leave Sunday after a woman tested negative for COVID-19.
Coronavirus: Princess cruise ship kept offshore now allowed to dock in Oakland
Princess Cruises said the ship will dock at the Port of Oakland some time on Monday.
Princess Cruises said the ship will dock at the Port of Oakland some time on Monday.
Carnival cruise ship suspends debarkation in Long Beach as crews investigate 'medical matter’
A Carnival cruise ship that docked in Long Beach is experiencing debarkation issues as crews onboard investigate a ‘medical matter’.
A Carnival cruise ship that docked in Long Beach is experiencing debarkation issues as crews onboard investigate a ‘medical matter’.
Coronavirus: 3 UCLA students under quarantine after testing for COVID-19
Three UCLA students that were being tested for coronavirus all tested negative for the disease, according to school officials.
Three UCLA students that were being tested for coronavirus all tested negative for the disease, according to school officials.
Some people receiving death threats due to coronavirus fears
As coronavirus deaths increase, so do death threats.
As coronavirus deaths increase, so do death threats.
L.A. County declares state of emergency amid 7 confirmed cases of COVID-19 coronavirus
Officials with the Los Angeles County Board of Supervisors and the Los Angeles County Department of Health declared a local public health emergency Wednesday morning.
Officials with the Los Angeles County Board of Supervisors and the Los Angeles County Department of Health declared a local public health emergency Wednesday morning.
First coronavirus death reported in California; person had been on cruise ship to Mexico
Doctors said this patient had minimal community exposure between returning from the cruise and arriving at the hospital by ambulance on Feb. 27.
Doctors said this patient had minimal community exposure between returning from the cruise and arriving at the hospital by ambulance on Feb. 27.
Coronavirus outbreak cuts short cruise from San Francisco to Mexico after passenger dies
Officials confirmed on Wednesday that a previous passenger who was exposed to the virus on a Grand Princess cruise ship has died.
Officials confirmed on Wednesday that a previous passenger who was exposed to the virus on a Grand Princess cruise ship has died.
U.S. virus death toll rises to 11 with California victim
The U.S. death toll from the coronavirus climbed to 11 on Wednesday with a victim succumbing in California.
The U.S. death toll from the coronavirus climbed to 11 on Wednesday with a victim succumbing in California.
Women holding 'let dairy die' signs storm stage at Biden Super Tuesday event
Two women stormed the stage as former Vice President Joe Biden's spoke at a Super Tuesday event.
Two women stormed the stage as former Vice President Joe Biden's spoke at a Super Tuesday event.
Vegan runner asks neighbors to close windows when cooking meat with 'offensive' odor
A self-proclaimed "vegan runner" from Berkeley, California received backlash on Saturday after asking neighbors to close their windows when cooking meat because the smells were 'overpowering and offensive.'
A self-proclaimed "vegan runner" from Berkeley, California received backlash on Saturday after asking neighbors to close their windows when cooking meat because the smells were 'overpowering and offensive.'
Homeowner uses motion-activated sprinkler with 'impressive amount of pressure' to thwart thieves
A California homeowner set up a motion-activated sprinkler to deter potential thieves in her neighborhood.
A California homeowner set up a motion-activated sprinkler to deter potential thieves in her neighborhood.
4 Irvine firefighters quarantined after making contact with patient showing coronavirus-like symptoms
Four Irvine firefighters with the Orange County Fire Authority were placed under quarantine at a local fire station after making contact with a patient who may have the COVID-19 coronavirus, it was announced Monday.
Four Irvine firefighters with the Orange County Fire Authority were placed under quarantine at a local fire station after making contact with a patient who may have the COVID-19 coronavirus, it was announced Monday.
Cruise ship coronavirus evacuees leave Travis Air Force Base
Of the cruise passengers, several dozen people had tested positive for the coronavirus, and they are being cared for at Bay Area hospitals, Fox reported.
Of the cruise passengers, several dozen people had tested positive for the coronavirus, and they are being cared for at Bay Area hospitals, Fox reported.
Baby born on Leap Day shares rare birthday with dad
A father in California shares a rare Feb. 29 birthday with his newborn daughter.
A father in California shares a rare Feb. 29 birthday with his newborn daughter.
Sanders in San Jose: Senator says he is stronger candidate than Biden
Sanders’ delegate lead over Joe Biden has shrunk from 30 to 8 after Biden’s big win in the South Carolina primary.
Sanders’ delegate lead over Joe Biden has shrunk from 30 to 8 after Biden’s big win in the South Carolina primary.